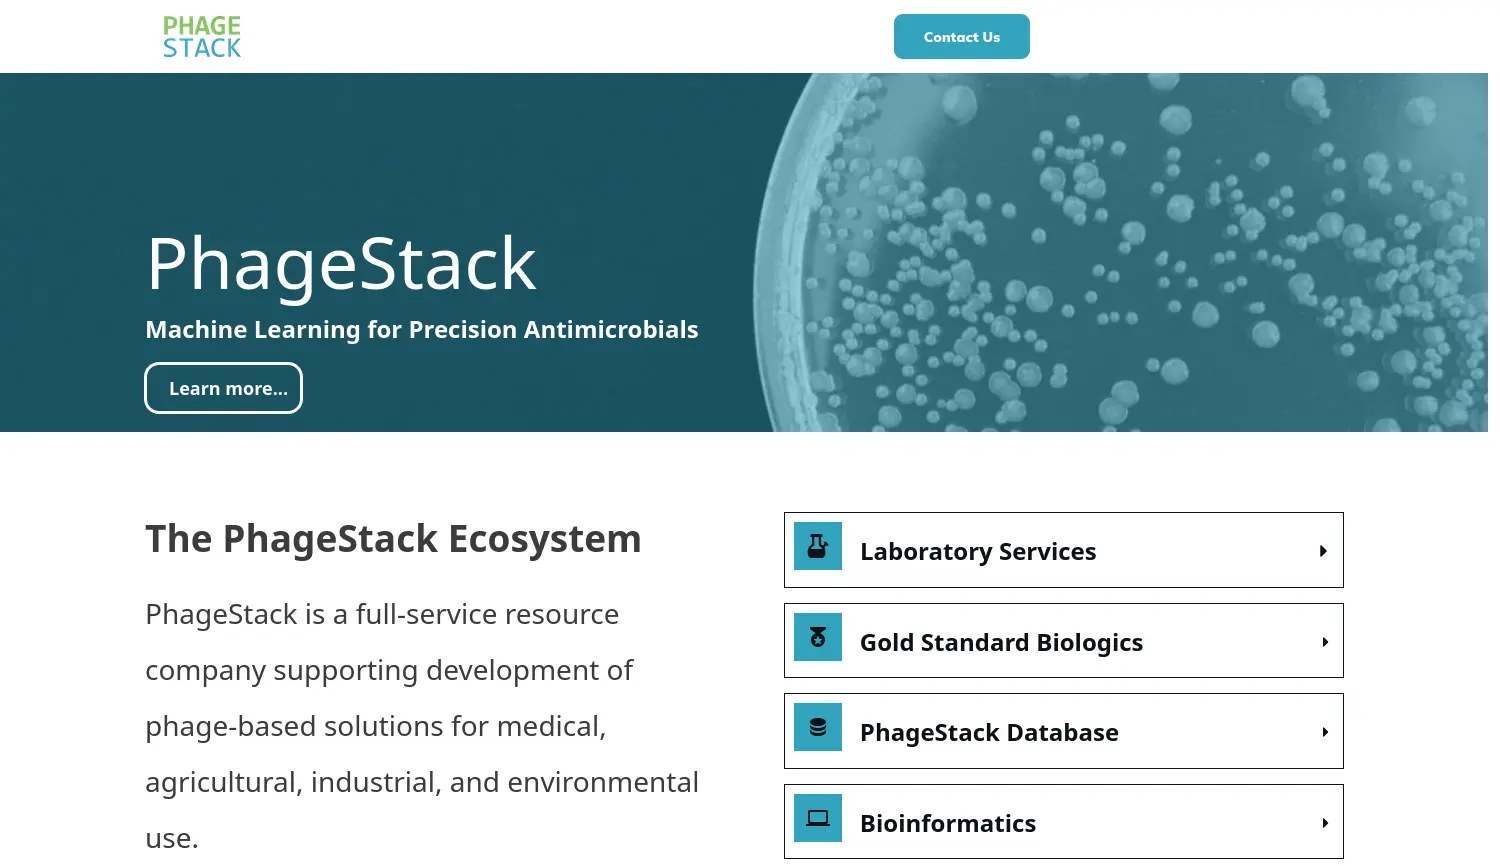
Website der Firma Phagestack GmbH

Phagestack
Die Zukunft der Antibiotika durch Präzisions-Phagentherapie
Phagestack kombiniert maschinelles Lernen mit Bioinformatik, um präzise antimikrobielle Therapien gegen antibiotikaresistente Bakterien zu entwickeln. Das Unternehmen bietet eine umfangreiche Phagen-Datenbank, Labordienstleistungen und validierte Biologika an. Ziel ist es, die herkömmliche Antibiotika-Entwicklung durch effizientere, zielgerichtete Lösungen zu ersetzen.
Über die Firma Phagestack GmbH
Phagestack ist ein im Jahr 2023 gegründetes Biotechnologie-Unternehmen, das an der Schnittstelle von maschinellem Lernen, Bioinformatik und Molekulargenetik agiert, um die herkömmliche Antibiotika-Entwicklung grundlegend zu verändern. Das Startup adressiert eines der drängendsten globalen Gesundheitsprobleme: die zunehmende Resistenz gegen Antibiotika (AMR). Durch den Einsatz von Künstlicher Intelligenz identifiziert das Team hochspezifische Bakteriophagen, die gezielt krankheitserregende Bakterien bekämpfen. Im Gegensatz zu herkömmlichen Breitbandantibiotika, die wie eine 'Atombombe' wirken, fungiert die Lösung von Phagestack wie ein 'Lichtschwert'. Dies bedeutet, dass nur die schädlichen Erreger vernichtet werden, während nützliche Bakterien und das menschliche Mikrobiom unversehrt bleiben. Damit leistet das Unternehmen einen entscheidenden Beitrag zur Patientensicherheit und zur Reduzierung von Nebenwirkungen.
Das Produktportfolio von Phagestack umfasst eine leistungsstarke Datenbank, die derzeit über 40.000 Einträge zu verschiedenen Phagentypen enthält. Diese Ressource wächst täglich durch kontinuierliche Isolation und Charakterisierung neuer Phagen in den eigenen Laboren. Zusätzlich zur Datenplattform bietet das Unternehmen spezialisierte Labordienstleistungen an, die auf Kundenwünsche zugeschnitten sind. Hierzu gehören die Phagenisolierung sowie die detaillierte bioinformatische Beschreibung genomischer Daten. Für Forscher und klinische Anwender stellt das Unternehmen zudem 'Gold Standard' Biologika zur Verfügung. Diese Präparate sind in vitro charakterisiert und sofort einsatzbereit für medizinische, landwirtschaftliche oder industrielle Projekte. Damit positioniert sich das Startup als ganzheitlicher Full-Service-Partner für die gesamte Phagenforschung.
Die Vision von Phagestack ist eine Welt, in der antimikrobielle Wirkstoffe nicht nur hocheffektiv, sondern auch nachhaltig und ökologisch verträglich sind. Über die Humanmedizin hinaus findet die Technologie Anwendung in der Aquakultur, der Landwirtschaft und der Lebensmittelproduktion, wo bakterielle Infektionen ebenfalls große Schäden anrichten. Das Unternehmen verfolgt das Ziel, Entwicklern weltweit datengestützte Werkzeuge an die Hand zu geben, um neue Therapien schneller und präziser auf den Markt zu bringen. Die Kombination aus tiefer biologischer Expertise und modernen Rechenmodellen macht Phagestack zu einem Pionier der Präzisionsmedizin. Durch die kontinuierliche Erweiterung des Phagen-Ecosystems sichert das Startup langfristig die Wirksamkeit medizinischer Behandlungen gegen multiresistente Keime. Das Engagement des Teams trägt dazu bei, die globale Gesundheitskrise durch resistente Krankheitserreger abzuwenden und innovative Heilmethoden zu etablieren.
#KünstlicheIntelligenz #Gesundheitswesen #Pharmazeutik #Medizintechnik #Biotech #MachineLearning #Bioinformatik #LifeSciences #Präzisionsmedizin #Mikrobiologie